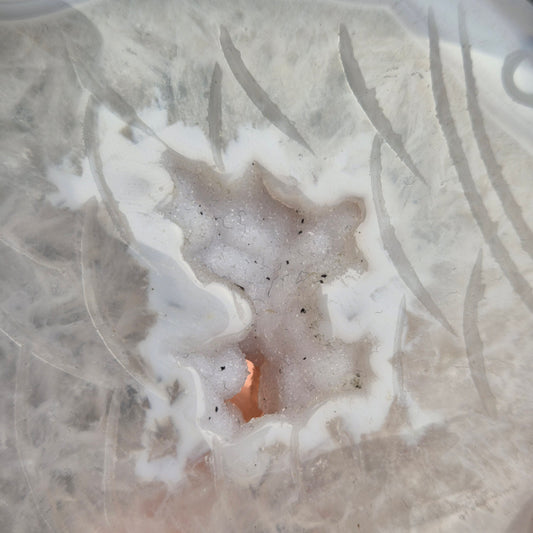

Collectie: Carvings
-
Green calcite / aragonite snail 2
Normale prijs €19,95 EURNormale prijsEenheidsprijs / perAanbiedingsprijs €19,95 EUR -
moss agate heart
Normale prijs €23,00 EURNormale prijsEenheidsprijs / perAanbiedingsprijs €23,00 EUR -
Green calcite / aragonite bunny 2
Normale prijs €14,95 EURNormale prijsEenheidsprijs / perAanbiedingsprijs €14,95 EUR -
Green calcite / aragonite bunny 1
Normale prijs €14,95 EURNormale prijsEenheidsprijs / perAanbiedingsprijs €14,95 EUR -
Silver sheen obsidian "butterfly" on stand 1
Normale prijs €34,95 EURNormale prijsEenheidsprijs / perAanbiedingsprijs €34,95 EUR -
Selenite diasy on stand
Normale prijs €24,95 EURNormale prijsEenheidsprijs / perAanbiedingsprijs €24,95 EUR -
Druzy agate fish 2
Normale prijs €39,95 EURNormale prijsEenheidsprijs / perAanbiedingsprijs €39,95 EUR -
Druzy agate fish 1
Normale prijs €39,95 EURNormale prijsEenheidsprijs / perAanbiedingsprijs €39,95 EUR -
Druzy agate butterfly on stand
Normale prijs €75,00 EURNormale prijsEenheidsprijs / perAanbiedingsprijs €75,00 EUR -
Lizardite heart 10
Normale prijs €25,00 EURNormale prijsEenheidsprijs / perAanbiedingsprijs €25,00 EUR -
Lizardite heart 9
Normale prijs €27,00 EURNormale prijsEenheidsprijs / perAanbiedingsprijs €27,00 EUR -
Lizardite heart 8
Normale prijs €27,00 EURNormale prijsEenheidsprijs / perAanbiedingsprijs €27,00 EUR -
Lizardite heart 7
Normale prijs €28,00 EURNormale prijsEenheidsprijs / perAanbiedingsprijs €28,00 EUR -
Lizardite heart 6
Normale prijs €27,00 EURNormale prijsEenheidsprijs / perAanbiedingsprijs €27,00 EUR -
Lizardite heart 5
Normale prijs €25,00 EURNormale prijsEenheidsprijs / perAanbiedingsprijs €25,00 EUR -
Lizardite heart 3
Normale prijs €23,00 EURNormale prijsEenheidsprijs / perAanbiedingsprijs €23,00 EUR -
Lizardite heart 2
Normale prijs €26,00 EURNormale prijsEenheidsprijs / perAanbiedingsprijs €26,00 EUR -
Black moonstone heart 9
Normale prijs €9,95 EURNormale prijsEenheidsprijs / perAanbiedingsprijs €9,95 EUR -
Black moonstone heart 1
Normale prijs €9,95 EURNormale prijsEenheidsprijs / perAanbiedingsprijs €9,95 EUR -
Pink peruvian rhodonite heart 8
Normale prijs €23,00 EURNormale prijsEenheidsprijs / perAanbiedingsprijs €23,00 EUR